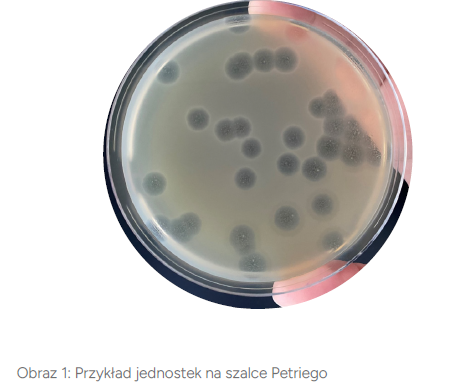

Śledzenie tego, co niewidoczne, czyli identyfikacja colifagów somatycznych we wszystkich rodzajach wody
W związku z ciągle rosnącymi wymaganiami dotyczącymi jakości wody pitnej oraz presją społeczną na ponowne wykorzystywanie oczyszczonych ścieków, colifagi somatyczne są monitorowane jako nowe wskaźniki oceny skuteczności procesów uzdatniania i oczyszczania wody. Dlatego tak ważne jest monitorowanie ich obecności w różnych typach wód, a zwłaszcza w wodzie przeznaczonej do spożycia przez ludzi.
Wstęp
Colifagi somatyczne stanowią obecnie ważny temat w kontroli jakości wody. Wynika to z faktu, iż wykazują pewne morfologiczne podobieństwo do ludzkich wirusów jelitowych, przez co mogą służyć jako potencjalne organizmy wskaźnikowe zanieczyszczenia wody wirusami. Colifagi somatyczne to wirusy infekujące bakterie, takie jak Escherichia coli, dzięki czemu stanowią doskonały wskaźnik zanieczyszczenia wody fekaliami. Mimo, że same w sobie nie są chorobotwórcze, colifagi somatyczne rozwijają się w podobnych warunkach i wykazują bardzo podobne zachowanie do wirusów stanowiących zagrożenie dla ludzkiego zdrowia. Patogenne wirusy jelitowe mogą wywoływać u ludzi bardzo nieprzyjemne zakaźne choroby przewodu pokarmowego. W związku z tym, jeśli w badanej wodzie zostaną wykryte colifagi somatyczne, istnieje wysokie prawdopodobieństwo, że obecne są w niej również wirusy chorobotwórcze.
Dlaczego badanie colifagów jest niezbędne?
Colifagi odgrywają kluczową rolę jako wskaźnik jakości wody. Ich obecność może sygnalizować potencjalne zagrożenia dla zdrowia publicznego, takie jak obecność wirusów i bakterii jelitowych.
Monitorowanie bakteriofagów somatycznych służy jako skuteczny system wczesnego ostrzegania przed zanieczyszczeniem ujęć wody fekaliami. W przypadku wykrycia podwyższonej zawartości tych wirusów, powinno wykonać się dalsze badania, mające na celu podjęcie działań interwencyjnych chroniących przed chorobami przenoszonymi drogą wodną. Co więcej, śledzenie poziomów colifagów somatycznych jest niezbędne do oceny skuteczności procesów uzdatniania wody, w tym dezynfekcji i filtracji, co równocześnie wpływa na ochronę jej jakości.
Zapewnienie zgodności z przepisami i normami sanitarnymi jakości wody przeznaczonej do spożycia i wody ciepłej jest kolejnym kluczowym aspektem ochrony zdrowia publicznego. Badania na colifagach somatycznych i ich zachowaniu w środowisku są ważne z punktu widzenia screeningu epidemiologicznego. Takie badania dostarczają cennych informacji na temat monitorowania chorób przenoszonych za pośrednictwem wody i mogą pomóc w opracowaniu strategii zapobiegania chorobom. Zrozumienie zwyczajów i zachowań colifagów w różnych warunkach środowiskowych pozwala nam na zapobieganie wybuchom ognisk epidemii.
Legislacja
Dyrektywa Parlamentu Europejskiego i Rady (UE) 2020/2184 z dnia 16 grudnia 2020r. dotycząca jakości wody przeznaczonej do spożycia przez ludzi weszła w życie 12 stycznia 2021r. Jest to całkowite przekształcenie dyrektywy 98/83WE. Wdrożenie jej do prawodawstwa krajowego zaplanowano na koniec 2022/2023 roku.
Bakteriofagi somatyczne są również wymienione w Rozporządzeniu Parlamentu Europejskiego i Rady (UE) 2020/741 z dnia 25 maja 2020r. w sprawie minimalnych wymagań dotyczących ponownego wykorzystania wody, które powinno zapewnić państwom członkowskim stosunkowo proste zasady ponownego wykorzystania oczyszczonej wody miejskiej.
Metodologia oznaczania colifagów somatycznych
Ponieważ colifagi somatyczne są wirusami, analizę wody przeprowadza się w zupełnie inny sposób niż oznaczanie parametrów bakteryjnych. Analiza jest o wiele bardziej złożona, wieloetapowa, gdzie konieczne jest trzymanie się zasad i warunków oraz określonych ram czasowych.

Pobieranie próbek i transport
Aby właściwie przeprowadzić analizę i dostarczyć klientom najwyższej jakości rzetelnych wyników, kluczowym jest zapewnienie:
- Odpowiedniej matrycy do badania: woda pitna, surowa, butelkowana, powierzchniowa, gruntowa, poprzemysłowa oraz ścieki.
Użycie odpowiedniego pojemnika na próbkę: do analizy colifagów stosuje się biały, plastikowy pojemnik o pojemności 500ml zawierający tiosiarczan sodu
(roztwór neutralizujący związki chloru). Neutralizacja chloru zapobiega śmierci żywych mikroorganizmów i fagów wrażliwych na jego obecność, a tym samym pozwala uniknąć fałszywie negatywnych wyników.- Minimalnej ilość próbki: wynosząca min. 200ml.
- Compliance with sutiable conditions during sample transport to the lab must be ensured: cooling of sample from 4 to 8°C.
Analizę należy przeprowadzić w ciągu trzech dni (czas przechowywania 72 godziny) od pobrania próbki. Z tego względu próbki należy dostarczyć do laboratorium ALS najpóźniej w czwartek rano w danym tygodniu.
Ocena wzrostu po inkubacji w jednostce PFU (Plaque Forming Unit, jednostka tworząca strefę przejaśnienia)

(A) Optymalna ilość PFU w celu oceny i możliwości
policzenia wyniku
(B) Graniczna ilość colifagów w celu ich oceny i
możliwości policzenia wyniku. Konieczne są
dalsze rozcieńczenia próbki. Technika filtracji
membranowej nie jest zalecana.
(C) Ilość colifagów jest niepoliczalna. Konieczne
wykonania ponownego badania uwzględniającego
kolejne rozcieńczenia próbki. Technika filtracji
membranowej nie jest zalecana
Referencje:
- Singh S., Pitchers R., Hassard F.: Coliphages as viral indicators of sanitary significance for drinking water. Frontiers in Microbiology (2022), 13.
DOI 10.3389/fmicb.2022.941532 - Zuzakova J., Janak D., Rihova Ambrozova J.: Concentration and enumeration methods of somatic coliphages in water samples. Vodohospodarske technicko-ekonomicke informace (2021), 63 (1), 3-13.
DOI 10.46555/VTEI.2020.11.002 - Jofre J., Lucena F., Blanch A.R., Muniesa M.: Coliphages as model ornasisms in the characterization and management of water resources. Water (2016), 8, 199.
DOI 10.3390/w8050199
